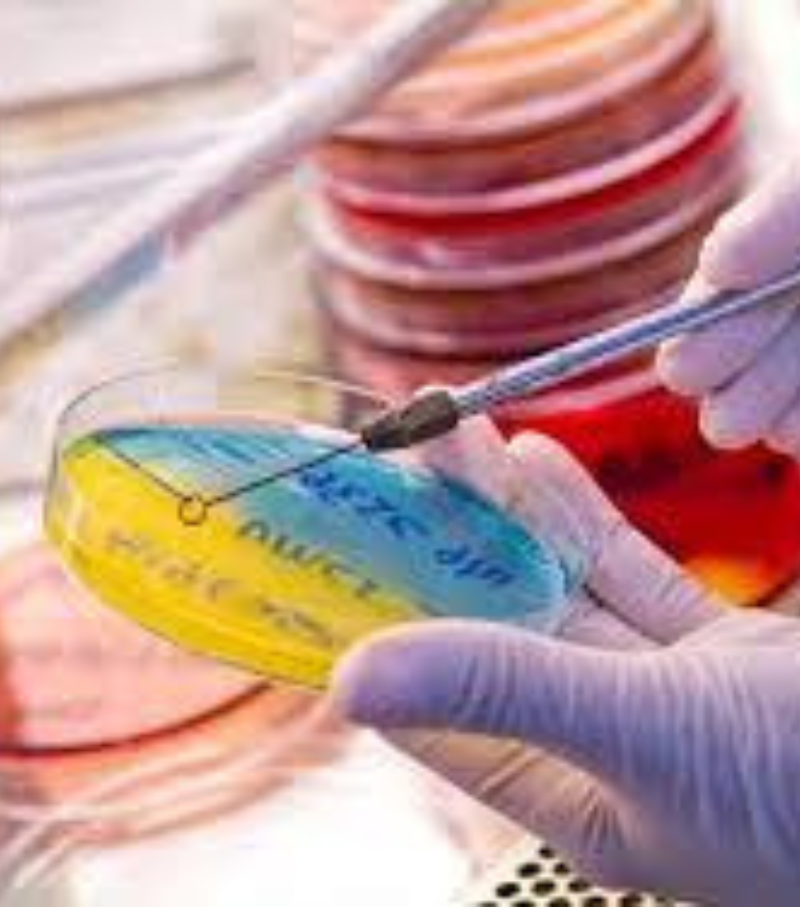
Microbiology

Genocare Scientific Pvt Ltd.
“your choice our promise”
Our motto is “your choice our promise” Geno care scientific having strong foothold in segments of Academia, Industry, Agriculture, Diagnostic, Medical and Seed Industry.

Genocare Scientific Pvt Ltd partners with global companies to offer advanced solutions in Cell Culture, Protein Research, Molecular Biology, Bioprocess, and Analytical Chemistry.
5 star reviews from our satisfied people.


Genocare scientific "your choice our promise"
Company Establishment year
No . Of Products Delivered
Monthly visitors for company
success growth in %
Genocare Scientific specializes in supplying microbiology, glassware, plasticware, and equipment.
Our vision is to be a globally trusted leader in providing high-quality pharmaceuticals and scientific instruments, driving advancements in healthcare and innovation.
Our mission is to deliver superior pharmaceutical, microbiology, and biotechnology products with integrity, reliability, innovation, and sustainable, long-term partnerships.
We offer a range of products, including microbiology tools, plasticware, equipment, biochemicals, and kits.
You can reach us by visiting our page.→Contact Us
